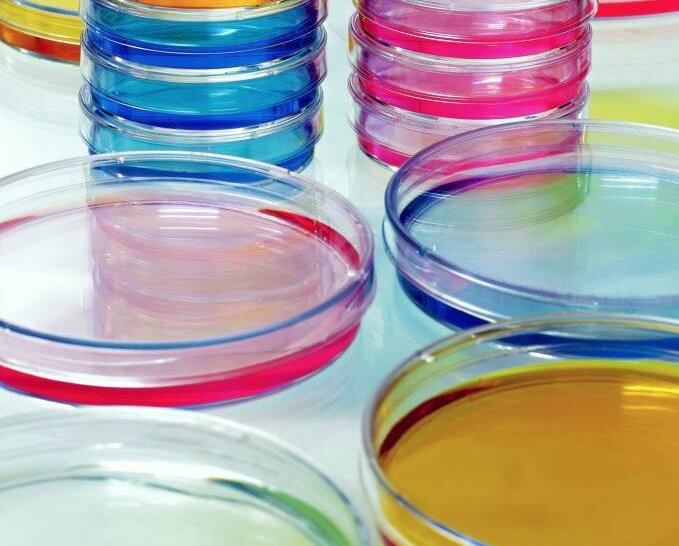

Antibiotika
MEILENSTEIN DER MEDIZINGESCHICHTE
Seite 1/1 4 Minuten
Eine Lungenentzündung, aber auch eine simple Wundinfektion konnte früher den sicheren Tod bedeuten, da man die krankheitserregenden Bakterien nicht wirksam bekämpfen konnte. Erst die Entdeckung und Entwicklung der Antibiotika führte dazu, dass ungezählte Leben gerettet und viele gängige Infektionskrankheiten plötzlich relativ leicht bekämpft werden konnten.
Die vergessene Petrischale August 1928: Der schottische Bakteriologe Alexander Fleming forscht am Londoner St. Mary’s Hospital bereits länger an Staphylokokken. Wie schon häufiger zuvor legt er auf einer Agarplatte eine Bakterienkultur an und stellt sie beiseite. Da Fleming aber nicht nur ein genialer Forscher, sondern leider auch außerordentlich unordentlich ist, landet diese Petrischale auf einer Bank in der Ecke seines Labors. Kurz darauf fährt er in die Sommerferien – die Petrischale hat er völlig vergessen.
Als er im September zurückkommt, findet er in ihr etwas Seltsames vor: Ein Schimmelpilz hat sich gebildet, in dessen Nähe sich keine Staphylokokken mehr finden. Fleming kultiviert diesen Schimmelpilz weiter und stellt fest, dass eines seiner Stoffwechselprodukte verschiedene krankheitserregende Bakterien abtötet – sogar noch in 800facher Verdünnung. Diese antibakterielle Substanz nennt Fleming „Penicillin“, denn der Pilz gehört zur Gruppe der Pinselschimmel .
Schädlich nur für Erreger Zwar war die Ursache vieler Infektionskrankheiten zu Anfang des 20. Jahrhunderts schon bekannt. Viele Substanzen, die man dagegen einsetzte, schädigten aber gleichzeitig das körpereigene Immunsystem, manchmal sogar so stark, dass sich die Mikroben noch ungehemmter vermehren konnten als zuvor. Fleming forschte schon lange daran, Stoffe zu finden, die das Wachstum von Bakterien hemmen oder sie abtöten, ohne den menschlichen Organismus zu schädigen.
1922 hatte er so bereits das Lysozym entdeckt, ein in Nasen- und Tränenflüssigkeit enthaltenes Enzym, welches das Wachstum von Mikroben hemmt. Allerdings war es nur gegen harmlosere Bakterien wirklich wirksam. Erst mit dem Penicillin fand Fleming eine wirksame Substanz, die nicht toxisch war. Das Penicillin bekämpfte gram-positive Bakterien wie Strepto-, Pneumo- oder Staphylokokken, nicht jedoch gram-negative, wie zum Beispiel das Typhusbakterium (Salmonella typhi).
Erstaunlich war jedoch, dass Penicillin auch gegen den Erreger der Gonorrhoe (Tripper) wirkte, obwohl es sich bei den Gonokokken um ein gram-negatives Bakterium handelt. Tatsächlich umfasst das Wirkspektrum von Penicillin neben gram-positiven Bakterien auch einige gram-negative Kokken und Spirochäten.
Weiterentwicklung in den 1940er-Jahren Fleming hörte zwar nicht auf, mit Penicillin zu experimentieren, kam dabei aber auch nicht recht voran. Die Zucht des Schimmelpilzes und die Gewinnung von Penicillin daraus war einfach zu umständlich und zeitaufwändig. 1940 gab er sich geschlagen: Bei diesem Aufwand eignete sich der Wirkstoff einfach nicht für einen breitflächigen medizinischen Einsatz. Kurz danach gelang es den Oxforder Forschern Ernst Boris Chain, Howard Florey, Edward Abraham und Norman Heatley, das Penicillin chemisch aus dem Kulturmedium zu isolieren.
Doch die Produktion war immer noch zu kompliziert. Weil man um das Potenzial des Medikaments für den Kriegseinsatz wusste, schalteten sich die USA in die Forschung ein. Dort gelang endlich die Massenproduktion, nachdem man neue, ergiebigere Pilzstämme gezüchtet und die Nährlösung optimiert hatte. Außerdem stellte man fest, dass es vier Arten von Penicillin gibt: F, G, X und K. Der schlussendliche Arzneiwirkstoff, Penicillin G, sicherte vielen Soldaten des Zweiten Weltkriegs das Überleben. 1945 erhielten Fleming, Florey und Chain für ihren Anteil an diesem Meilenstein der Medizingeschichte gemeinsam den Nobelpreis.
Nicht der Erste Gemeinhin gilt Fleming als der Entdecker des Penicillins, doch tatsächlich kannten schon andere vor ihm seine Wirkung. So isolierte bereits 1893 der italienische Arzt Bartolomeo Gosio eine Substanz aus einem Pilz der Gattung Penicillium, die das Wachstum von Milzbranderregern hemmte. Seine Veröffentlichungen fanden jedoch keine Beachtung, in erster Linie wohl, weil sie auf Italienisch verfasst waren.
1897 schrieb der französische Militärarzt Ernest Duchesne eine Doktorarbeit über die antibiotische Wirkung von Schimmelpilzen. Er war in einem Militärhospital auf arabische Stallburschen aufmerksam geworden, die die Sättel in dunklen, feuchten Räumen lagerten, damit sie Schimmel ansetzen. Sie behaupteten, die Scheuerwunden an den Pferderücken würden dadurch schneller abheilen. Duchesne experimentierte daraufhin mit Kolibakterien und einem Penicilliumstamm und fand heraus, dass dieser das Wachstum der Bakterien unterdrückte.
Doch die Zeit war noch nicht reif für diese Entdeckung des erst 23-Jährigen und seine Doktorarbeit wurde abgelehnt. Als viel beschäftigter Militärarzt fehlte ihm die Zeit, weiter zu forschen und er verstarb bereits im Alter von 37 Jahren. Erste synthetische antibiotische Wirkstoffe wurden bereits Anfang des 20. Jahrhunderts erforscht und hergestellt. Dabei handelte es sich um Chemotherapeutika wie die Arsenverbindung Arsphenamin, die erfolgreich gegen Syphilis eingesetzt wurde, oder Sulfamidochrysoidin aus der Gruppe der Sulfonamide, das hauptsächlich bei Wundinfektionen Anwendung fand. Da diese Substanzen starke Nebenwirkungen hatten, wurden sie später weitgehend vom Penicillin verdrängt.
Viele unterschiedliche Gruppen Mittlerweile kennt man fast achttausend antibiotisch wirkende Substanzen. Etwa achtzig davon werden in der Medizin angewandt. Weit über 2000 antibiotikahaltige Arzneimittel gibt es bereits – und es werden immer mehr. Denn so bahnbrechend, wie die Entdeckung der Antibiotika war: Bakterien sind anpassungsfähig und entwickeln schnell Resistenzen, auch gegen diese Wunderwaffe der Medizin.
Der übermäßige Einsatz von Antibiotika in der Vergangenheit könnte sich heute rächen. Denn wenn irgendwann Bakterienstämme entstehen, die gegen jedes bekannte Antibiotikum resistent sind, könnten harmlose Infektionskrankheiten wieder das werden, was sie früher einmal waren: eine tödliche Gefahr.
Den Artikel finden Sie auch in Die PTA IN DER APOTHEKE 08/14 ab Seite 76.
Dr. Holger Stumpf, Medizinjournalist